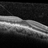
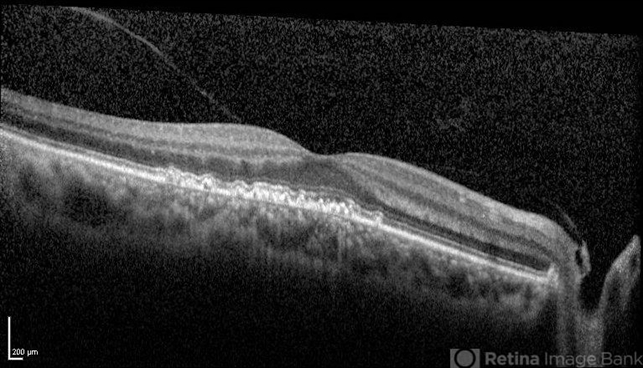

-
By Gerardo Garcia-Aguirre, MD
By Gerardo Garcia-Aguirre, MD
Asociacion para Evitar la Ceguera en Mexico - Uploaded on Jun 28, 2018.
- Last modified by Caroline Bozell on Jun 28, 2018.
- Rating
- Appears in
- Miscellaneous
- Condition/keywords
- cuticular drusen
- Description
- Cuticular drusen.

Initializing download.
Initializing download.










